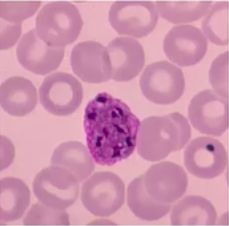
Flashcard 2 image

Following is an egg of: _____

Which form of Plasmodium spp. is seen here? _____
The following organism is _____
The following is an egg of _____
Following is an egg of: _____

Following is an egg of: _____

Following is an egg of: _____

Following is an egg of: _____

Following is an egg of: _____

Following is an egg of: _____

Classification of Parasites
Flashcards
Intestinal Protozoa
Flashcards
Blood and Tissue Protozoa
Flashcards
Malaria Parasites
Flashcards
Leishmaniasis
Flashcards
Intestinal Helminths: Nematodes
Flashcards
Tissue Nematodes
Flashcards
Trematodes
Flashcards
Cestodes
Flashcards
Ectoparasites
Flashcards
Antiparasitic Drugs
Flashcards
Laboratory Diagnosis of Parasitic Infections
Flashcards
These Parasitology flashcards are designed for NEET-PG Microbiology preparation, using active recall to help you retain high-yield concepts, clinical correlations, and commonly tested facts. Each card prompts you to retrieve information from memory rather than passively reviewing notes, which research shows leads to significantly better exam performance.
The 251 cards in this deck cover the most important topics in Parasitology, including key mechanisms, diagnostic criteria, treatment protocols, and clinical pearls that frequently appear in NEET-PG examinations. Cards are organised by chapter so you can focus on specific areas or work through the entire topic systematically.
For personalised spaced repetition scheduling that adapts to your performance, unlimited flashcards, and detailed progress analytics, download the Oncourse app.
Get full access to all flashcards, spaced repetition, and progress tracking.
Start For Free